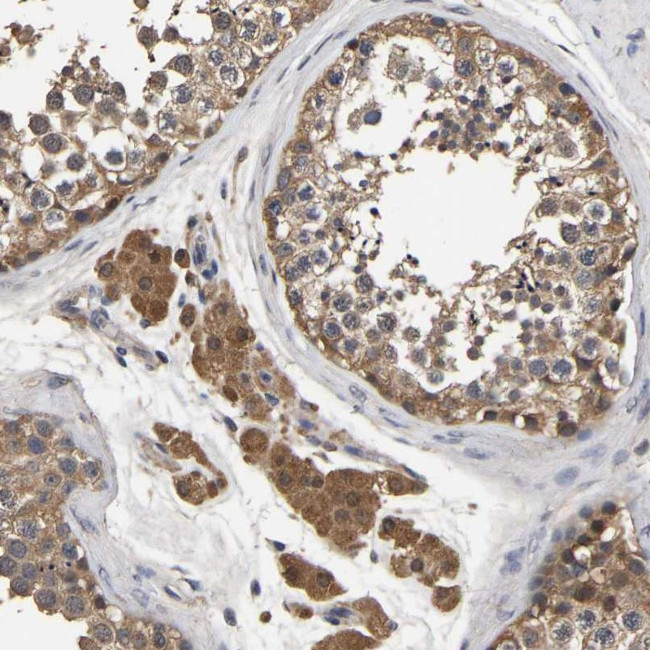
STK32C Antibody in Immunohistochemistry (Paraffin) (IHC (P))

Search
Invitrogen
STK32C Polyclonal Antibody
{{$productOrderCtrl.translations['antibody.pdp.commerceCard.promotion.promotions']}}
{{$productOrderCtrl.translations['antibody.pdp.commerceCard.promotion.viewpromo']}}
{{$productOrderCtrl.translations['antibody.pdp.commerceCard.promotion.promocode']}}: {{promo.promoCode}} {{promo.promoTitle}} {{promo.promoDescription}}. {{$productOrderCtrl.translations['antibody.pdp.commerceCard.promotion.learnmore']}}
产品信息
PA5-53662
种属反应
宿主/亚型
分类
类型
抗原
偶联物
形式
浓度
规格
纯化类型
保存液
内含物
保存条件
运输条件
RRID
产品详细信息
Immunogen sequence: PTFELEEMIL ESRPLHKKKK RLAKNKSRDN SRDSSQSEND YLQDCLDAIQ QDFVIFNREK LKRSQDLPRE PLPAPESRDA AEPVEDEAER SALPMCGPIC PS
Highest antigen sequence identity to the following orthologs: Mouse - 83%, Rat - 83%.
靶标信息
STK32C or YANK3 is a member of the YANK family and is a serine/threonine protein kinase of approximately 486 aa that requires magnesium for catalytic activity. There are two isoforms of the protein generated by alternative splicing and the protein undergoes serine phosphorylation by upstream protein kinases. The STK32C gene product is conserved in many species including chimpanzee, dog, cow, mouse, rat, and chicken.
仅用于科研。不用于诊断过程。未经明确授权不得转售。
篇参考文献 (0)
生物信息学
蛋白别名: PKE; PKE protein kinase; RP11-140A10.1; Serine/threonine-protein kinase 32C; testicular tissue protein Li 187; unnamed protein product; Yet another novel kinase 3
基因别名: PKE; STK32C; YANK3
UniProt ID: (Human) Q86UX6
Entrez Gene ID: (Human) 282974